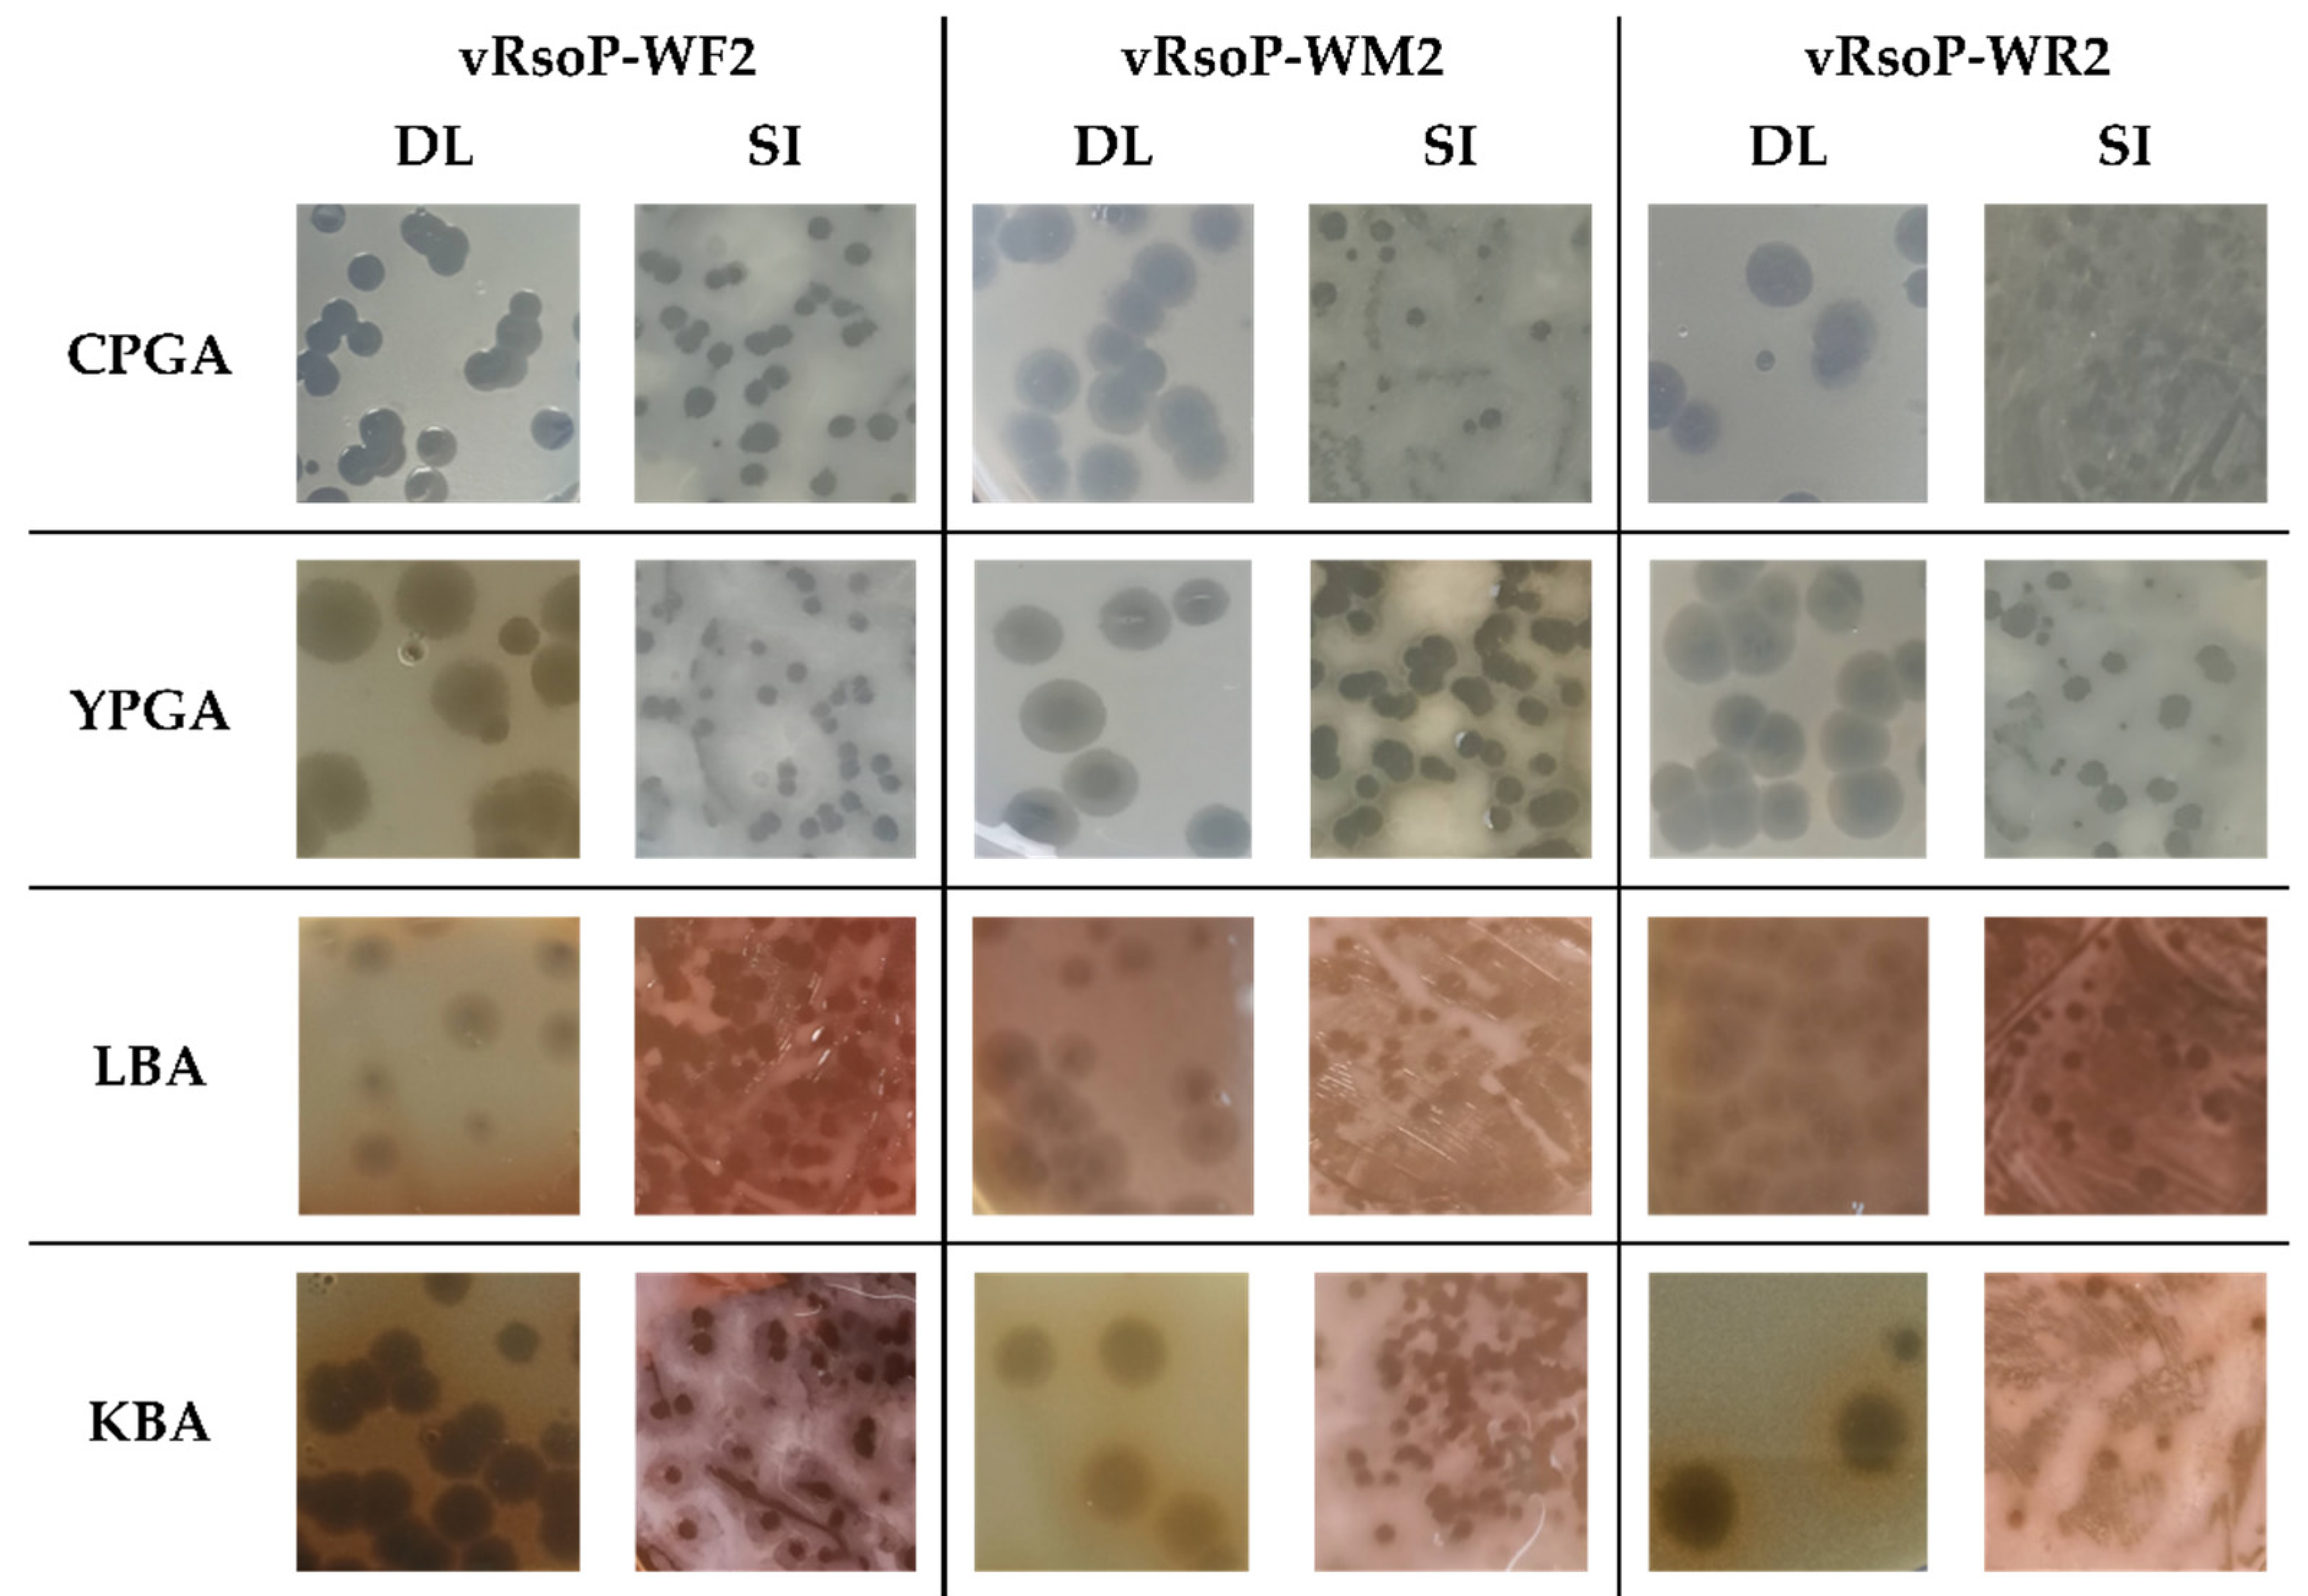
Viruses 13 02539 g001

Genomic Analysis of the First European Bacteriophages with Depolymerase Activity and Biocontrol Efficacy against the Phytopathogen Ralstonia solanacearum
Abstract
1. Introduction
2. Materials and Methods
2.1. Bacterium, Phages, and Growth Conditions
2.2. Phage Lytic and Depolymerase Activities
2.3. Phage Morphology
2.4. Phage DNA Isolation and Genome Sequencing
2.5. Phage Genome Bioinformatic Analysis
2.5.1. De Novo Assembly
2.5.2. Genome Annotation
2.5.3. Phylogenetic Analysis
3. Results
3.1. Phage Plaque Morphology, Lytic and Depolymerase Activities
3.2. Phage Virion Morphology
3.3. Phage Genomic Analysis
3.4. Phage Classification
4. Discussion
5. Conclusions
Supplementary Materials
Author Contributions
Funding
Institutional Review Board Statement
Informed Consent Statement
Data Availability Statement
Acknowledgments
Conflicts of Interest
References
- Elphinstone, J.G. The current bacterial wilt situation: A global overview. In Bacterial Wilt Disease and the Ralstonia solanacearum Species Complex; Allen, C., Prior, P., Hayward, A.C., Eds.; APS Press: St. Paul, MI, USA, 2005; pp. 9–28. [Google Scholar]
- Mansfield, J.; Genin, S.; Magori, S.; Citovsky, V.; Sriariyanum, M.; Ronald, P.; Dow, M.; Verdier, V.; Beer, S.V.; Machado, M.A.; et al. Top 10 plant pathogenic bacteria in molecular plant pathology. Mol. Plant Pathol. 2012, 13, 614–629. [Google Scholar] [CrossRef] [PubMed]
- Álvarez, B.; Biosca, E.G.; López, M.M. On the life of Ralstonia solanacearum, a destructive bacterial plant pathogen. In Current Research, Technology and Education Topics in Applied Microbiology and Microbial Biotechnology; Méndez-Vilas, A., Ed.; Formatex: Badajoz, Spain, 2010; pp. 267–279. [Google Scholar]
- Álvarez, B.; Biosca, E.G. Bacteriophage-based bacterial wilt biocontrol for an environmentally sustainable agriculture. Front. Plant Sci. 2017, 8, 1218. [Google Scholar] [CrossRef]
- Álvarez, B.; López, M.M.; Biosca, E.G. Biocontrol of the major plant pathogen Ralstonia solanacearum in irrigation water and host plants by novel waterborne lytic bacteriophages. Front. Microbiol. 2019, 10, 2813. [Google Scholar] [CrossRef]
- EFSA Panel on Plant Health (EFSA PLH Panel); Bragard, C.; Dehnen-Schmutz, K.; Di Serio, F.; Gonthier, P.; Jaques Miret, J.A.; Justesen, A.F.; MacLeod, A.; Magnusson, C.S.; Milonas, P.; et al. Pest categorisation of the Ralstonia solanacearum species complex. EFSA J. 2019, 17. [Google Scholar] [CrossRef]
- Olsson, K. Experience of brown rot caused by Pseudomonas solanacearum (Smith) Smith in Sweden. EPPO Bull. 1976, 6, 199–207. [Google Scholar] [CrossRef]
- Fegan, M.; Prior, P. How complex is the Ralstonia solanacearum species complex? In Bacterial Wilt Disease and the Ralstonia solanacearum Species Complex; Allen, C., Prior, P., Hayward, A.C., Eds.; APS Press: St. Paul, MI, USA, 2005. [Google Scholar]
- Cellier, G.; Prior, P. Deciphering phenotypic diversity of Ralstonia solanacearum strains pathogenic to potato. Phytopathology 2010, 100, 1250–1261. [Google Scholar] [CrossRef] [PubMed]
- Caruso, P.; Palomo, J.L.; Bertolini, E.; Alvarez, B.; López, M.M.; Biosca, E.G. Seasonal variation of Ralstonia solanacearum biovar 2 populations in a Spanish river: Recovery of stressed cells at low temperatures. Appl. Environ. Microbiol. 2005, 71, 140–148. [Google Scholar] [CrossRef] [PubMed]
- Caruso, P.; Biosca, E.G.; Bertolini, E.; Marco-Noales, E.; Gorris, M.T.; Licciardello, C.; López, M.M. Genetic diversity reflects geographical origin of Ralstonia solanacearum strains isolated from plant and water sources in Spain. Int. Microbiol. Off. J. Span. Soc. Microbiol. 2017, 20, 155–164. [Google Scholar] [CrossRef]
- Biosca, E.G.; Caruso, P.; Bertolini, E.; Álvarez, B.; Palomo, J.L.; Gorris, M.T.; López, M.M. Improved detection of Ralstonia solanacearum in culturable and VBNC state from water samples at low temperatures. In Bacterial Wilt Disease and the Ralstonia solanacearum Species Complex; Allen, C., Prior, P., Hayward, A.C., Eds.; APS Press: St. Paul, MI, USA, 2005; pp. 501–506. [Google Scholar]
- Stevens, P.; van Elsas, J.D. Genetic and phenotypic diversity of Ralstonia solanacearum biovar 2 strains obtained from Dutch waterways. Antonie Van Leeuwenhoek 2010, 97, 171–188. [Google Scholar] [CrossRef]
- Cruz, L.; Eloy, M.; Quirino, F.; Oliveira, H.; Tenreiro, R. Molecular epidemiology of Ralstonia solanacearum strains from plants and environmental sources in Portugal. Eur. J. Plant Pathol. 2012, 133, 687–706. [Google Scholar] [CrossRef]
- Parkinson, N.; Bryant, R.; Bew, J.; Conyers, C.; Stones, R.; Alcock, M.; Elphinstone, J. Application of variable-number tandem-repeat typing to discriminate Ralstonia solanacearum strains associated with English watercourses and disease outbreaks. Appl. Environ. Microbiol. 2013, 79, 6016–6022. [Google Scholar] [CrossRef]
- Safni, I.; Cleenwerck, I.; De Vos, P.; Fegan, M.; Sly, L.; Kappler, U. Polyphasic taxonomic revision of the Ralstonia solanacearum species complex: Proposal to emend the descriptions of Ralstonia solanacearum and Ralstonia syzygii and reclassify current R. syzygii strains as Ralstonia syzygii subsp. syzygii subsp. nov., R. solanacearum phylotype IV strains as Ralstonia syzygii subsp. indonesiensis subsp. nov., banana blood disease bacterium strains as Ralstonia syzygii subsp. celebesensis subsp. nov. and R. solanacearum phylotype I and III strains as Ralstonia pseudosolanacearum sp. nov. Int. J. Syst. Evol. Microbiol. 2014, 64, 3087–3103. [Google Scholar] [CrossRef]
- EPPO Global Database. Available online: https://gd.eppo.int (accessed on 5 September 2021).
- Smith, E.F. A Bacterial Disease of the Tomato, Eggplant, and Irish Potato (Bacillus solanacearum n. sp.); G.P.O.: Washington, DC, USA, 2016; Volume 12. [Google Scholar]
- Yuliar; Nion, Y.A.; Toyota, K. Recent trends in control methods for bacterial wilt diseases caused by Ralstonia solanacearum. Microbes Environ. 2015, 30, 1–11. [Google Scholar] [CrossRef] [PubMed]
- Buttimer, C.; McAuliffe, O.; Ross, R.P.; Hill, C.; O’Mahony, J.; Coffey, A. Bacteriophages and bacterial plant diseases. Front. Microbiol. 2017, 8, 34. [Google Scholar] [CrossRef]
- Holtappels, D.; Fortuna, K.; Lavigne, R.; Wagemans, J. The future of phage biocontrol in integrated plant protection for sustainable crop production. Curr. Opin. Biotechnol. 2021, 68, 60–71. [Google Scholar] [CrossRef]
- Jamal, M.; Bukhari, S.M.; Andleeb, S.; Ali, M.; Raza, S.; Nawaz, M.A.; Hussain, T.; Rahman, S.U.; Shah, S.S.A. Bacteriophages: An overview of the control strategies against multiple bacterial infections in different fields. J. Basic Microbiol. 2019, 59, 123–133. [Google Scholar] [CrossRef]
- Svircev, A.; Roach, D.; Castle, A. Framing the future with bacteriophages in agriculture. Viruses 2018, 10, 218. [Google Scholar] [CrossRef] [PubMed]
- González Biosca, E.; López González, M.M.; Álvarez Ortega, B. Procedimiento para la Prevención y/o el Control Biológico de la Marchitez causada por Ralstonia solanacearum, a través del Uso de Bacteriófagos Útiles para Ello y Composiciones de los Mismos. Spain Patent ES2592352B2, 7 October 2017. [Google Scholar]
- González Biosca, E.; López González, M.M.; Álvarez Ortega, B. Method for the Prevention and/or the Biological Control of Bacterial Wilt caused by Ralstonia solanacearum, via the Use of Bacteriophages Suitable for this Purpose and Compositions thereof. U.S. Patent US10508266B2, 17 December 2019. [Google Scholar]
- González Biosca, E.; López González, M.M.; Álvarez Ortega, B. Method for the Prevention and/or the Biological Control of Wilt caused by Ralstonia solanacearum. Eur. Patent EP3305892B1, 9 September 2020. [Google Scholar]
- Horita, M.; Tsuchiya, K. Causal agent of bacterial wilt disease Ralstonia solanacearum. In MAFF Microorganism Genetic Resources Manual No. 12; National Institute of Agricultural Sciences: Tsukuba, Japan, 2002; pp. 5–8. [Google Scholar]
- Miller, H. Practical aspects of preparing phage and plasmid DNA: Growth, maintenance, and storage of bacteria and bacteriophage. In Methods in Enzymology; Elsevier: Amsterdam, The Netherlands, 1987; Volume 152, pp. 145–170. ISBN 978-0-12-182053-4. [Google Scholar]
- Sambrook, J.; Russel, D.W. Molecular cloning: A laboratory Manual; Cold Spring Harbor Laboratory Press: New York, NY, USA.
- Lelliott, R.A.; Stead, D.E. Methods for the diagnosis of bacterial diseases of plants. In Methods in Plant Pathology; Blackwell Scientific Publications: Oxford, UK, 1987. [Google Scholar]
- King, E.O.; Ward, M.K.; Raney, D.E. Two simple media for the demonstration of pyocyanin and fluorescin. J. Lab. Clin. Med. 1954, 44, 301–307. [Google Scholar]
- Bolger, A.M.; Lohse, M.; Usadel, B. Trimmomatic: A flexible trimmer for Illumina sequence data. Bioinformatics 2014, 30, 2114–2120. [Google Scholar] [CrossRef] [PubMed]
- Wick, R.R.; Judd, L.M.; Gorrie, C.L.; Holt, K.E. Unicycler: Resolving bacterial genome assemblies from short and long sequencing reads. PLOS Comput. Biol. 2017, 13, e1005595. [Google Scholar] [CrossRef]
- Bankevich, A.; Nurk, S.; Antipov, D.; Gurevich, A.A.; Dvorkin, M.; Kulikov, A.S.; Lesin, V.M.; Nikolenko, S.I.; Pham, S.; Prjibelski, A.D.; et al. SPAdes: A new genome assembly algorithm and its applications to single-cell sequencing. J. Comput. Biol. 2012, 19, 455–477. [Google Scholar] [CrossRef]
- Walker, B.J.; Abeel, T.; Shea, T.; Priest, M.; Abouelliel, A.; Sakthikumar, S.; Cuomo, C.A.; Zeng, Q.; Wortman, J.; Young, S.K.; et al. Pilon: An integrated tool for comprehensive microbial variant detection and genome assembly improvement. PLoS ONE 2014, 9, e112963. [Google Scholar] [CrossRef] [PubMed]
- Brettin, T.; Davis, J.J.; Disz, T.; Edwards, R.A.; Gerdes, S.; Olsen, G.J.; Olson, R.; Overbeek, R.; Parrello, B.; Pusch, G.D.; et al. RASTtk: A modular and extensible implementation of the RAST algorithm for building custom annotation pipelines and annotating batches of genomes. Sci. Rep. 2015, 5, 8365. [Google Scholar] [CrossRef] [PubMed]
- Delcher, A.L.; Bratke, K.A.; Powers, E.C.; Salzberg, S.L. Identifying bacterial genes and endosymbiont DNA with glimmer. Bioinformatics 2007, 23, 673–679. [Google Scholar] [CrossRef] [PubMed]
- Hyatt, D.; Chen, G.-L.; LoCascio, P.F.; Land, M.L.; Larimer, F.W.; Hauser, L.J. Prodigal: Prokaryotic gene recognition and translation initiation site identification. BMC Bioinform. 2010, 11, 119. [Google Scholar] [CrossRef]
- NCBI Resource Coordinators; Agarwala, R.; Barrett, T.; Beck, J.; Benson, D.A.; Bollin, C.; Bolton, E.; Bourexis, D.; Brister, J.R.; Bryant, S.H.; et al. Database resources of the National Center for Biotechnology Information. Nucleic Acids Res. 2018, 46, D8–D13. [Google Scholar] [CrossRef]
- Zimmermann, L.; Stephens, A.; Nam, S.-Z.; Rau, D.; Kübler, J.; Lozajic, M.; Gabler, F.; Söding, J.; Lupas, A.N.; Alva, V. A Completely reimplemented MPI bioinformatics toolkit with a new HHpred server at its core. J. Mol. Biol. 2018, 430, 2237–2243. [Google Scholar] [CrossRef]
- Lopes, A.; Tavares, P.; Petit, M.-A.; Guérois, R.; Zinn-Justin, S. Automated classification of tailed bacteriophages according to their neck organization. BMC Genom. 2014, 15, 1027. [Google Scholar] [CrossRef]
- Blum, M.; Chang, H.-Y.; Chuguransky, S.; Grego, T.; Kandasaamy, S.; Mitchell, A.; Nuka, G.; Paysan-Lafosse, T.; Qureshi, M.; Raj, S.; et al. The InterPro protein families and domains database: 20 years on. Nucleic Acids Res. 2021, 49, D344–D354. [Google Scholar] [CrossRef]
- Krogh, A.; Larsson, B.; von Heijne, G.; Sonnhammer, E.L. Predicting transmembrane protein topology with a hidden markov model: Application to complete genomes. J. Mol. Biol. 2001, 305, 567–580. [Google Scholar] [CrossRef] [PubMed]
- De Nies, L.; Lopes, S.; Busi, S.B.; Galata, V.; Heintz-Buschart, A.; Laczny, C.C.; May, P.; Wilmes, P. PathoFact: A pipeline for the prediction of virulence factors and antimicrobial resistance genes in metagenomic data. Microbiome 2021, 9, 49. [Google Scholar] [CrossRef] [PubMed]
- Chen, L. VFDB: A reference database for bacterial virulence factors. Nucleic Acids Res. 2004, 33, D325–D328. [Google Scholar] [CrossRef]
- Wei, C.; Liu, J.; Maina, A.N.; Mwaura, F.B.; Yu, J.; Yan, C.; Zhang, R.; Wei, H. Developing a bacteriophage cocktail for biocontrol of potato bacterial wilt. Virol. Sin. 2017, 32, 476–484. [Google Scholar] [CrossRef]
- Ahmad, A.A.; Elhalag, K.M.; Addy, H.S.; Nasr-Eldin, M.A.; Hussien, A.S.; Huang, Q. Sequencing, genome analysis and host range of a novel Ralstonia phage, RsoP1EGY, isolated in Egypt. Arch. Virol. 2018, 163, 2271–2274. [Google Scholar] [CrossRef]
- Da Silva Xavier, A.; da Silva, F.P.; Vidigal, P.M.P.; Lima, T.T.M.; de Souza, F.O.; Alfenas-Zerbini, P. Genomic and biological characterization of a new member of the genus Phikmvvirus infecting phytopathogenic Ralstonia bacteria. Arch. Virol. 2018, 163, 3275–3290. [Google Scholar] [CrossRef]
- Trotereau, A.; Boyer, C.; Bornard, I.; Pécheur, M.J.B.; Schouler, C.; Torres-Barceló, C. High genomic diversity of novel phages infecting the plant pathogen Ralstonia solanacearum, isolated in Mauritius and Reunion islands. Sci. Rep. 2021, 11, 5382. [Google Scholar] [CrossRef] [PubMed]
- Kawasaki, T.; Narulita, E.; Matsunami, M.; Ishikawa, H.; Shimizu, M.; Fujie, M.; Bhunchoth, A.; Phironrit, N.; Chatchawankanphanich, O.; Yamada, T. Genomic diversity of large-plaque-forming podoviruses infecting the phytopathogen Ralstonia solanacearum. Virology 2016, 492, 73–81. [Google Scholar] [CrossRef] [PubMed]
- Addy, H.S.; Farid, M.M.; Ahmad, A.A.; Huang, Q. Host range and molecular characterization of a lytic Pradovirus-like Ralstonia phage RsoP1IDN isolated from Indonesia. Arch. Virol. 2018, 163, 3409–3414. [Google Scholar] [CrossRef]
- Lee, S.Y.; Thapa Magar, R.; Kim, H.J.; Choi, K.; Lee, S.-W. Complete genome sequence of a novel bacteriophage RpY1 infecting Ralstonia solanacearum strains. Curr. Microbiol. 2021, 78, 2044–2050. [Google Scholar] [CrossRef]
- Meier-Kolthoff, J.P.; Göker, M. VICTOR: Genome-based phylogeny and classification of prokaryotic viruses. Bioinformatics 2017, 33, 3396–3404. [Google Scholar] [CrossRef]
- Moraru, C.; Varsani, A.; Kropinski, A.M. VIRIDIC-A novel tool to calculate the intergenomic similarities of prokaryote-infecting viruses. Viruses 2020, 12, 1268. [Google Scholar] [CrossRef] [PubMed]
- Nishimura, Y.; Yoshida, T.; Kuronishi, M.; Uehara, H.; Ogata, H.; Goto, S. ViPTree: The viral proteomic tree server. Bioinformatics 2017, 33, 2379–2380. [Google Scholar] [CrossRef]
- Casjens, S.R.; Gilcrease, E.B. Determining DNA packaging strategy by analysis of the termini of the chromosomes in tailed-bacteriophage virions. In Bacteriophages; Clokie, M.R.J., Kropinski, A.M., Eds.; Methods in Molecular Biology; Humana Press: Totowa, NJ, USA, 2009; Volume 502, pp. 91–111. ISBN 978-1-60327-564-4. [Google Scholar]
- Merrill, B.D.; Ward, A.T.; Grose, J.H.; Hope, S. Software-based analysis of bacteriophage genomes, physical ends, and packaging strategies. BMC Genomics 2016, 17, 679. [Google Scholar] [CrossRef] [PubMed]
- Guindon, S.; Dufayard, J.-F.; Lefort, V.; Anisimova, M.; Hordijk, W.; Gascuel, O. New algorithms and methods to estimate maximum-likelihood phylogenies: Assessing the performance of PhyML 3.0. Syst. Biol. 2010, 59, 307–321. [Google Scholar] [CrossRef] [PubMed]
- Lefort, V.; Longueville, J.-E.; Gascuel, O. SMS: Smart model selection in PhyML. Mol. Biol. Evol. 2017, 34, 2422–2424. [Google Scholar] [CrossRef]
- Letunic, I.; Bork, P. Interactive tree of life (ITOL) v5: An online tool for phylogenetic tree display and annotation. Nucleic Acids Res. 2021, 49, W293–W296. [Google Scholar] [CrossRef]
- Terzian, P.; Olo Ndela, E.; Galiez, C.; Lossouarn, J.; Pérez Bucio, R.E.; Mom, R.; Toussaint, A.; Petit, M.-A.; Enault, F. PHROG: Families of prokaryotic virus proteins clustered using remote homology. NAR Genom. Bioinforma. 2021, 3, lqab067. [Google Scholar] [CrossRef]
- Sullivan, M.J.; Petty, N.K.; Beatson, S.A. Easyfig: A genome comparison visualizer. Bioinforma. Oxf. Engl. 2011, 27, 1009–1010. [Google Scholar] [CrossRef]
- Szymczak, M.; Grygorcewicz, B.; Karczewska-Golec, J.; Decewicz, P.; Pankowski, J.A.; Országh-Szturo, H.; Bącal, P.; Dołęgowska, B.; Golec, P. Characterization of a unique Bordetella bronchiseptica vB_BbrP_BB8 bacteriophage and its application as an antibacterial agent. Int. J. Mol. Sci. 2020, 21, 1403. [Google Scholar] [CrossRef]
- Kala, S.; Cumby, N.; Sadowski, P.D.; Hyder, B.Z.; Kanelis, V.; Davidson, A.R.; Maxwell, K.L. HNH proteins are a widespread component of phage DNA packaging machines. Proc. Natl. Acad. Sci. USA 2014, 111, 6022–6027. [Google Scholar] [CrossRef]
- Miller, R.C.; Lee, M.; Scraba, D.G.; Paetkau, V. The role of bacteriophage T7 exonuclease (gene 6) in genetic recombination and production of concatemers. J. Mol. Biol. 1976, 101, 223–234. [Google Scholar] [CrossRef]
- Molineux, I.J.; Panja, D. Popping the cork: Mechanisms of phage genome ejection. Nat. Rev. Microbiol. 2013, 11, 194–204. [Google Scholar] [CrossRef]
- Lella, M.; Kamilla, S.; Jain, V.; Mahalakshmi, R. Molecular mechanism of holin transmembrane domain I in pore formation and bacterial cell death. ACS Chem. Biol. 2016, 11, 910–920. [Google Scholar] [CrossRef] [PubMed]
- Cahill, J.; Rajaure, M.; O’Leary, C.; Sloan, J.; Marrufo, A.; Holt, A.; Kulkarni, A.; Hernandez, O.; Young, R. Genetic analysis of the Lambda spanins Rz and Rz1: Identification of functional domains. G3 Genes|Genomes|Genetics 2017, 7, 741–753. [Google Scholar] [CrossRef]
- Wu, Y.; Wang, R.; Xu, M.; Liu, Y.; Zhu, X.; Qiu, J.; Liu, Q.; He, P.; Li, Q. A novel polysaccharide depolymerase encoded by the phage SH-KP152226 confers specific activity against multidrug-resistant Klebsiella pneumoniae via biofilm degradation. Front. Microbiol. 2019, 10, 2768. [Google Scholar] [CrossRef] [PubMed]
- Almpanis, A.; Swain, M.; Gatherer, D.; McEwan, N. Correlation between bacterial G+C content, genome size and the G+C content of associated plasmids and bacteriophages. Microb. Genom. 2018, 4, e000168. [Google Scholar] [CrossRef]
- Rocha, E.P.C.; Danchin, A. Base composition bias might result from competition for metabolic resources. Trends Genet. TIG 2002, 18, 291–294. [Google Scholar] [CrossRef]
- Lavigne, R.; Seto, D.; Mahadevan, P.; Ackermann, H.-W.; Kropinski, A.M. Unifying classical and molecular taxonomic classification: Analysis of the Podoviridae using BLASTP-based tools. Res. Microbiol. 2008, 159, 406–414. [Google Scholar] [CrossRef]
- Fernandes, S.; São-José, C. Enzymes and mechanisms employed by tailed bacteriophages to breach the bacterial cell barriers. Viruses 2018, 10, 396. [Google Scholar] [CrossRef]
- Matamp, N.; Bhat, S. Phage endolysins as potential antimicrobials against multidrug resistant Vibrio alginolyticus and Vibrio parahaemolyticus: Current status of research and challenges ahead. Microorganisms 2019, 7, 84. [Google Scholar] [CrossRef]
- Denny, T.P.; Baek, S.-R. Genetic evidence that extracellular polysaccharide is a virulence factor of Pseudomonas solanacearum. Mol. Plant. Microbe Interact. 1991, 4, 198–206. [Google Scholar] [CrossRef]
- Genin, S.; Denny, T.P. Pathogenomics of the Ralstonia solanacearum species complex. Annu. Rev. Phytopathol. 2012, 50, 67–89. [Google Scholar] [CrossRef]
- Denny, T.P. Involvement of bacterial polysaccharides in plant pathogenesis. Annu. Rev. Phytopathol. 1995, 33, 173–197. [Google Scholar] [CrossRef] [PubMed]
- Saile, E.; McGarvey, J.A.; Schell, M.A.; Denny, T.P. Role of extracellular polysaccharide and endoglucanase in root invasion and colonization of tomato plants by Ralstonia solanacearum. Phytopathology 1997, 87, 1264–1271. [Google Scholar] [CrossRef] [PubMed]
- Born, Y.; Fieseler, L.; Klumpp, J.; Eugster, M.R.; Zurfluh, K.; Duffy, B.; Loessner, M.J. The tail-associated depolymerase of Erwinia amylovora phage L1 mediates host cell adsorption and enzymatic capsule removal, which can enhance infection by other phage. Environ. Microbiol. 2014, 16, 2168–2180. [Google Scholar] [CrossRef]
- Pires, D.P.; Oliveira, H.; Melo, L.D.R.; Sillankorva, S.; Azeredo, J. Bacteriophage-encoded depolymerases: Their diversity and biotechnological applications. Appl. Microbiol. Biotechnol. 2016, 100, 2141–2151. [Google Scholar] [CrossRef] [PubMed]
- Malnoy, M.; Faize, M.; Venisse, J.-S.; Geider, K.; Chevreau, E. Expression of viral EPS-depolymerase reduces fire blight susceptibility in transgenic pear. Plant Cell Rep. 2005, 23, 632–638. [Google Scholar] [CrossRef]
- Knecht, L.E.; Veljkovic, M.; Fieseler, L. Diversity and function of phage encoded depolymerases. Front. Microbiol. 2019, 10, 2949. [Google Scholar] [CrossRef]
- Latka, A.; Maciejewska, B.; Majkowska-Skrobek, G.; Briers, Y.; Drulis-Kawa, Z. Bacteriophage-encoded virion-associated enzymes to overcome the carbohydrate barriers during the infection process. Appl. Microbiol. Biotechnol. 2017, 101, 3103–3119. [Google Scholar] [CrossRef]
- Casjens, S.R.; Gilcrease, E.B.; Winn-Stapley, D.A.; Schicklmaier, P.; Schmieger, H.; Pedulla, M.L.; Ford, M.E.; Houtz, J.M.; Hatfull, G.F.; Hendrix, R.W. The generalized transducing Salmonella bacteriophage ES18: Complete genome sequence and DNA packaging strategy. J. Bacteriol. 2005, 187, 1091–1104. [Google Scholar] [CrossRef]
- Garneau, J.R.; Depardieu, F.; Fortier, L.-C.; Bikard, D.; Monot, M. PhageTerm: A tool for fast and accurate determination of phage termini and packaging mechanism using next-generation sequencing data. Sci. Rep. 2017, 7, 8292. [Google Scholar] [CrossRef] [PubMed]
- Hendrix, R.W.; Smith, M.C.; Burns, R.N.; Ford, M.E.; Hatfull, G.F. Evolutionary relationships among diverse bacteriophages and prophages: All the world’s a phage. Proc. Natl. Acad. Sci. USA 1999, 96, 2192–2197. [Google Scholar] [CrossRef] [PubMed]

| Phage | Length | GC-Contents | Annotated Proteins | GenBank Accession Number |
|---|---|---|---|---|
| vRsoP-WF2 | 40,690 bp | 59.07% | 52 | MN685189 |
| vRsoP-WM2 | 40,688 bp | 59.10% | 52 | MN685190 |
| vRsoP-WR2 | 41,158 bp | 59.04% | 53 | MN685191 |
| ORF Number | Predicted Function | ||
|---|---|---|---|
| vRsoP-WF2 | vRsoP-WM2 | vRsoP-WR2 | |
| 1 | 1 | 1 | |
| 2 | 2 | 2 | |
| 3 | 3 | 3 | |
| 4 | 4 | 4 | |
| 5 | 5 | 5 | |
| 6 | 6 | 6 | |
| 7 | 7 | 7 | |
| 8 | 8 | 8 | |
| 9 | 9 | 9 | |
| 10 | 10 | 10 | |
| 11 | 11 | 11 | |
| 12 | 12 | 12 | |
| 13 | 13 | 13 | |
| 14 | 14 | 14 | Phage integrase, tyrosine recombinase |
| 15 | 15 | 15 | Phage HNH homing endonuclease |
| 16 | 16 | 16 | Phage DNA-directed RNA polymerase |
| - | - | 17 | Phage restriction endonuclease |
| 17 | 17 | 18 | |
| 18 | 18 | 19 | Phage single-stranded DNA-binding protein |
| 19 | 19 | 20 | Phage endonuclease I |
| 20 | 20 | 21 | Phage endolysin |
| 21 | 21 | 22 | |
| 22 | 22 | 23 | Phage restriction endonuclease |
| 23 | 23 | 24 | Phage primase/helicase protein |
| 24 | 24 | 25 | |
| 25 | 25 | 26 | |
| 26 | 26 | 27 | Phage DNA-directed DNA polymerase |
| 27 | 27 | 28 | |
| 28 | 28 | 29 | |
| 29 | 29 | 30 | |
| 30 | 30 | 31 | Phage exonuclease |
| 31 | 31 | 32 | |
| 32 | 32 | 33 | |
| 33 | 33 | 34 | |
| 34 | 34 | 35 | |
| 35 | 35 | 36 | Phage collar, head-to-tail connector protein |
| 36 | 36 | 37 | Phage capsid assembly protein |
| 37 | 37 | 38 | |
| 38 | 38 | 39 | Phage capsid and scaffold protein |
| 39 | 39 | 40 | Phage endonuclease VII |
| 40 | 40 | 41 | Phage major capsid protein |
| 41 | 41 | 42 | |
| 42 | 42 | 43 | Phage tail tubular protein |
| 43 | 43 | 44 | Phage non-contractile tail tubular protein |
| 44 | 44 | 45 | Phage protein, probable scaffold protein |
| 45 | 45 | 46 | |
| 46 | 46 | 47 | |
| 47 | 47 | 48 | Phage DNA ejectosome component, peptidoglycan lytic exotransglycosylase |
| 48 | 48 | 49 | Phage tail fiber protein, pectin-lyase fold |
| 49 | 49 | 50 | |
| 50 | 50 | 51 | Phage terminase small subunit |
| 51 | 51 | 52 | |
| 52 | 52 | 53 | Phage terminase large subunit |
Publisher’s Note: MDPI stays neutral with regard to jurisdictional claims in published maps and institutional affiliations. |
© 2021 by the authors. Licensee MDPI, Basel, Switzerland. This article is an open access article distributed under the terms and conditions of the Creative Commons Attribution (CC BY) license (https://creativecommons.org/licenses/by/4.0/).
Share and Cite
Biosca, E.G.; Català-Senent, J.F.; Figàs-Segura, À.; Bertolini, E.; López, M.M.; Álvarez, B. Genomic Analysis of the First European Bacteriophages with Depolymerase Activity and Biocontrol Efficacy against the Phytopathogen Ralstonia solanacearum. Viruses 2021, 13, 2539. https://doi.org/10.3390/v13122539
Biosca EG, Català-Senent JF, Figàs-Segura À, Bertolini E, López MM, Álvarez B. Genomic Analysis of the First European Bacteriophages with Depolymerase Activity and Biocontrol Efficacy against the Phytopathogen Ralstonia solanacearum. Viruses. 2021; 13(12):2539. https://doi.org/10.3390/v13122539
Chicago/Turabian StyleBiosca, Elena G., José Francisco Català-Senent, Àngela Figàs-Segura, Edson Bertolini, María M. López, and Belén Álvarez. 2021. "Genomic Analysis of the First European Bacteriophages with Depolymerase Activity and Biocontrol Efficacy against the Phytopathogen Ralstonia solanacearum" Viruses 13, no. 12: 2539. https://doi.org/10.3390/v13122539
APA StyleBiosca, E. G., Català-Senent, J. F., Figàs-Segura, À., Bertolini, E., López, M. M., & Álvarez, B. (2021). Genomic Analysis of the First European Bacteriophages with Depolymerase Activity and Biocontrol Efficacy against the Phytopathogen Ralstonia solanacearum. Viruses, 13(12), 2539. https://doi.org/10.3390/v13122539

